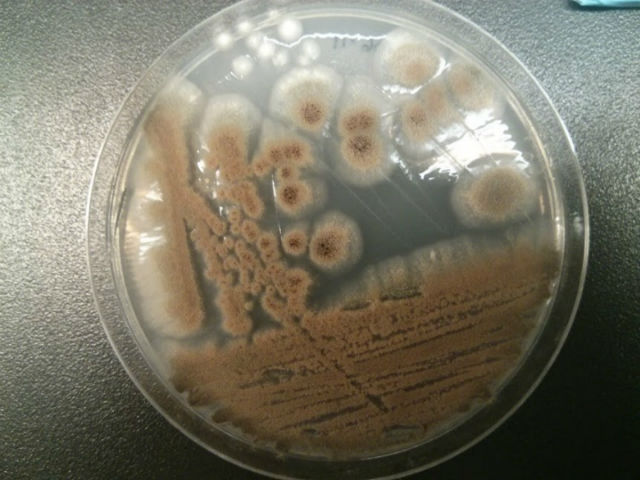
Для проведения экспериментов учёные выделили молекулу АМА из грибка вида Aspergillus versicolor (фото McMaster University).

Одними из самых выносливых грибков на планете считаются те, что содержат в себе молекулу коротко именующуюся AMA (она обезвреживает один из самых опасных генов, который помогает микроорганизмам противостоять антибиотикам). Такие грибки особенно распространёны в Новой Шотландии, но встречаются в любых географических широтах, от Арктики до Мёртвого моря, и их высокая живучесть привлекла внимание исследователей.
Биологи изучили природу грибков с молекулой АМА и пришли к выводу, что они способны восстановить эффективность антибиотиков.
"Наше открытие позволит решить один из аспектов крупной проблемы современности. Молекулы АМА восстанавливают активность антибиотиков карбапенемов, что крайне важно для медицины", — говорит ведущий автор исследования Джерри Райт (Gerry Wright) из университета МакМастер в Канаде.

Сегодня одной из главных медицинских проблем признана устойчивость болезнетворных бактерий к новым поколениям антибиотиков. Фармацевтические компании пытаются разрешить её путём создания комбинированных лекарств (сам антибиотик и препарат, ослабляющий защиту от него). Но такой подход может привести к отказу печени и других органов у пациентов.
Бактерии, которые также ведут войну за своё существование и постоянно эволюционируют, способны разорвать химическое кольцо большинства антибиотиков, из-за чего нейтрализуется эффект от приёма лекарства. Использование молекулы AMA восходит к предыдущей стратегии объединения антибиотиков с блокировщиками активности бактерий, разница состоит лишь в том, что на этот раз учёные попытались найти молекулу, которая может блокировать бактериальные ферменты.
"Натуральные продукты, в особенности те, что имеют микробное происхождения, то есть созданные из бактерий и грибков, являются ключом к решению проблемы. Эти продукты являются результатом эволюции самих патогенов, и потому они гораздо лучше взаимодействуют с бактериями", — поясняет Райт в пресс-релизе.
Исследователи проверили 500 природных молекул и 30 тысяч синтетических соединений и обнаружили, что АМА ингибирует ген NDM-1 у бактерий, имеющих устойчивость к антибиотикам. Всемирная организация здравоохранения признала фермент NDM-1 глобальной угрозой здоровью населения, но теперь эта угроза выглядит не столь устрашающей.
Учёные провели эксперимент на мышах, в ходе которого животных заразили пневмонией с геном NDM-1 (то есть грызуны должны были умереть, несмотря на антибиотиковую терапию). Введение в организм грызунов молекулы АМА подавило экспрессию опасного гена и ускорило ход лечения.
По словам экспертов, грибки, как дополнительный "лекарственный препарат" может быть только временной мерой. В ходе эволюции патогены выработают устойчивость и к АМА, однако к тому моменту исследователи смогут разработать новые методы терапии.
Также по теме:
В Великобритании определили самую насущную проблему современности
У устойчивых к антибиотикам бактерий нашли ахиллесову пяту
Устойчивые формы бактерий можно победить чередованием антибиотиков
Бактерия болезни Лайма оказалась старше человеческого рода
Голландские химики разрабатывают управляемый антибиотик



















































































